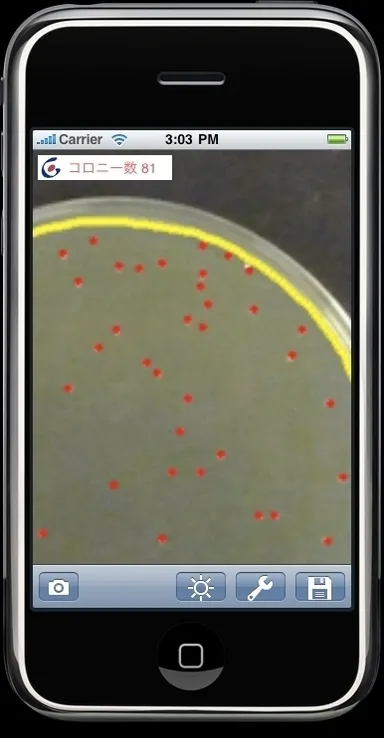
「HG／生菌数カウンタ」

ハイパーギア、バイオ用ソフト第一弾! iPhone用コロニーカウンタ 「HG/生菌数カウンタ」を配布開始
~生命科学実験、食品衛生管理検査などに必須の生菌数の計数を スマートフォンだけで自動化~
サービス
2010年6月22日 13:00株式会社ハイパーギア(本社:埼玉県さいたま市、代表取締役:本田 克己)は、アップル社のスマートフォンiPhone上で細菌数の自動計数をおこなう、「HG/生菌数カウンタ」を開発し、6月末より、App Storeからダウンロード公開します。生命科学実験、食品衛生管理検査などに必須のシャーレで培養した生菌数(コロニー数)の計数を、iPhone内蔵カメラで撮影するだけで自動的におこない、結果を表示します。
近年、遺伝子工学、DNA技術などバイオテクノロジと総称される生命工学が発展していますが、その基礎実験のひとつである、細菌を培養してその数を数えるという作業では、目視により人手でカウントする方法が多く取られています。食品衛生管理などでは、細菌検査として生菌数の測定も日々多数行なわれていますが、自動化には高価で、大型の自動コロニーカウンタなどの装置が必要でした。
「HG/生菌数カウンタ」は、iPhoneのカメラで、細菌を培養しているシャーレを撮影するだけで、スマートフォン内部で画像処理し、2、3秒でコロニーの自動判定を行い、その数を計数し、撮影画像に重ねて表示します。自動操作なので誤りなく、高速で実験を行なうことができます。また有償版では、その結果を画像として保管できますのでレポート作成も容易です。誤認識がある場合も、iPhoneの画面をタップするなどの操作で誤認識したコロニーを手動で訂正して計数するなど、すべての操作をiPhoneだけで行なうことができます。本ソフトウェアは立命館大学生命科学部今中研究室のご指導の下、開発いたしました。
●特長
・iPhoneだけですべて処理
シャーレの撮影から、画像処理、認識結果の修正、画像保存までiPhoneだけで可能です。
デジタルカメラで撮影してパソコンに送るなどの手間も不要で、専用計数装置のような大型機器も不要です。
・独自の画像処理技術により、高速で高精度認識
iPhone上のプロセッサだけで、2、3秒で画像認識し、計数します。
●機能
・画像取り込み :内蔵カメラ/外部ファイルから取り込み可能です。
・シャーレ認識 :コロニーをカウントするための領域を自動判定します(黄色で表示)。
・コロニー自動認識:画像の統計量によりコントラストなどの自動補正をし、認識します。
・コロニー自動計数:認識したコロニー数を計数して、画像上に表示します(赤色で表示)。
・手動調整 :画像の明るさをスライダで調整できます。
・手動認識 :誤認識がある場合、そのコロニーをタップすることにより削除、追加できます。
・画像保存 :認識結果をカウント数と同時に画像として保存できます(有償版のみ)。
●販売価格
無償版:画像の保存機能を除き、すべての機能が使えます。
有償版:ダウンロード価格 3,000円(税込)を予定
●公開開始等
2010年6月末 App Store登録予定
http://www.hypergear.com/catalog/catalog-pdf/BIO/HGcolonycounter_RevD.pdf
iPhoneはアップル社の登録商標です。
【お問い合わせ】
販売 : 株式会社ハイパーギア バイオ事業部
TEL : 03-5225-7531
FAX : 03-5225-6512
E-Mail: bio@hypergear.com
URL : http://www.hypergear.com/